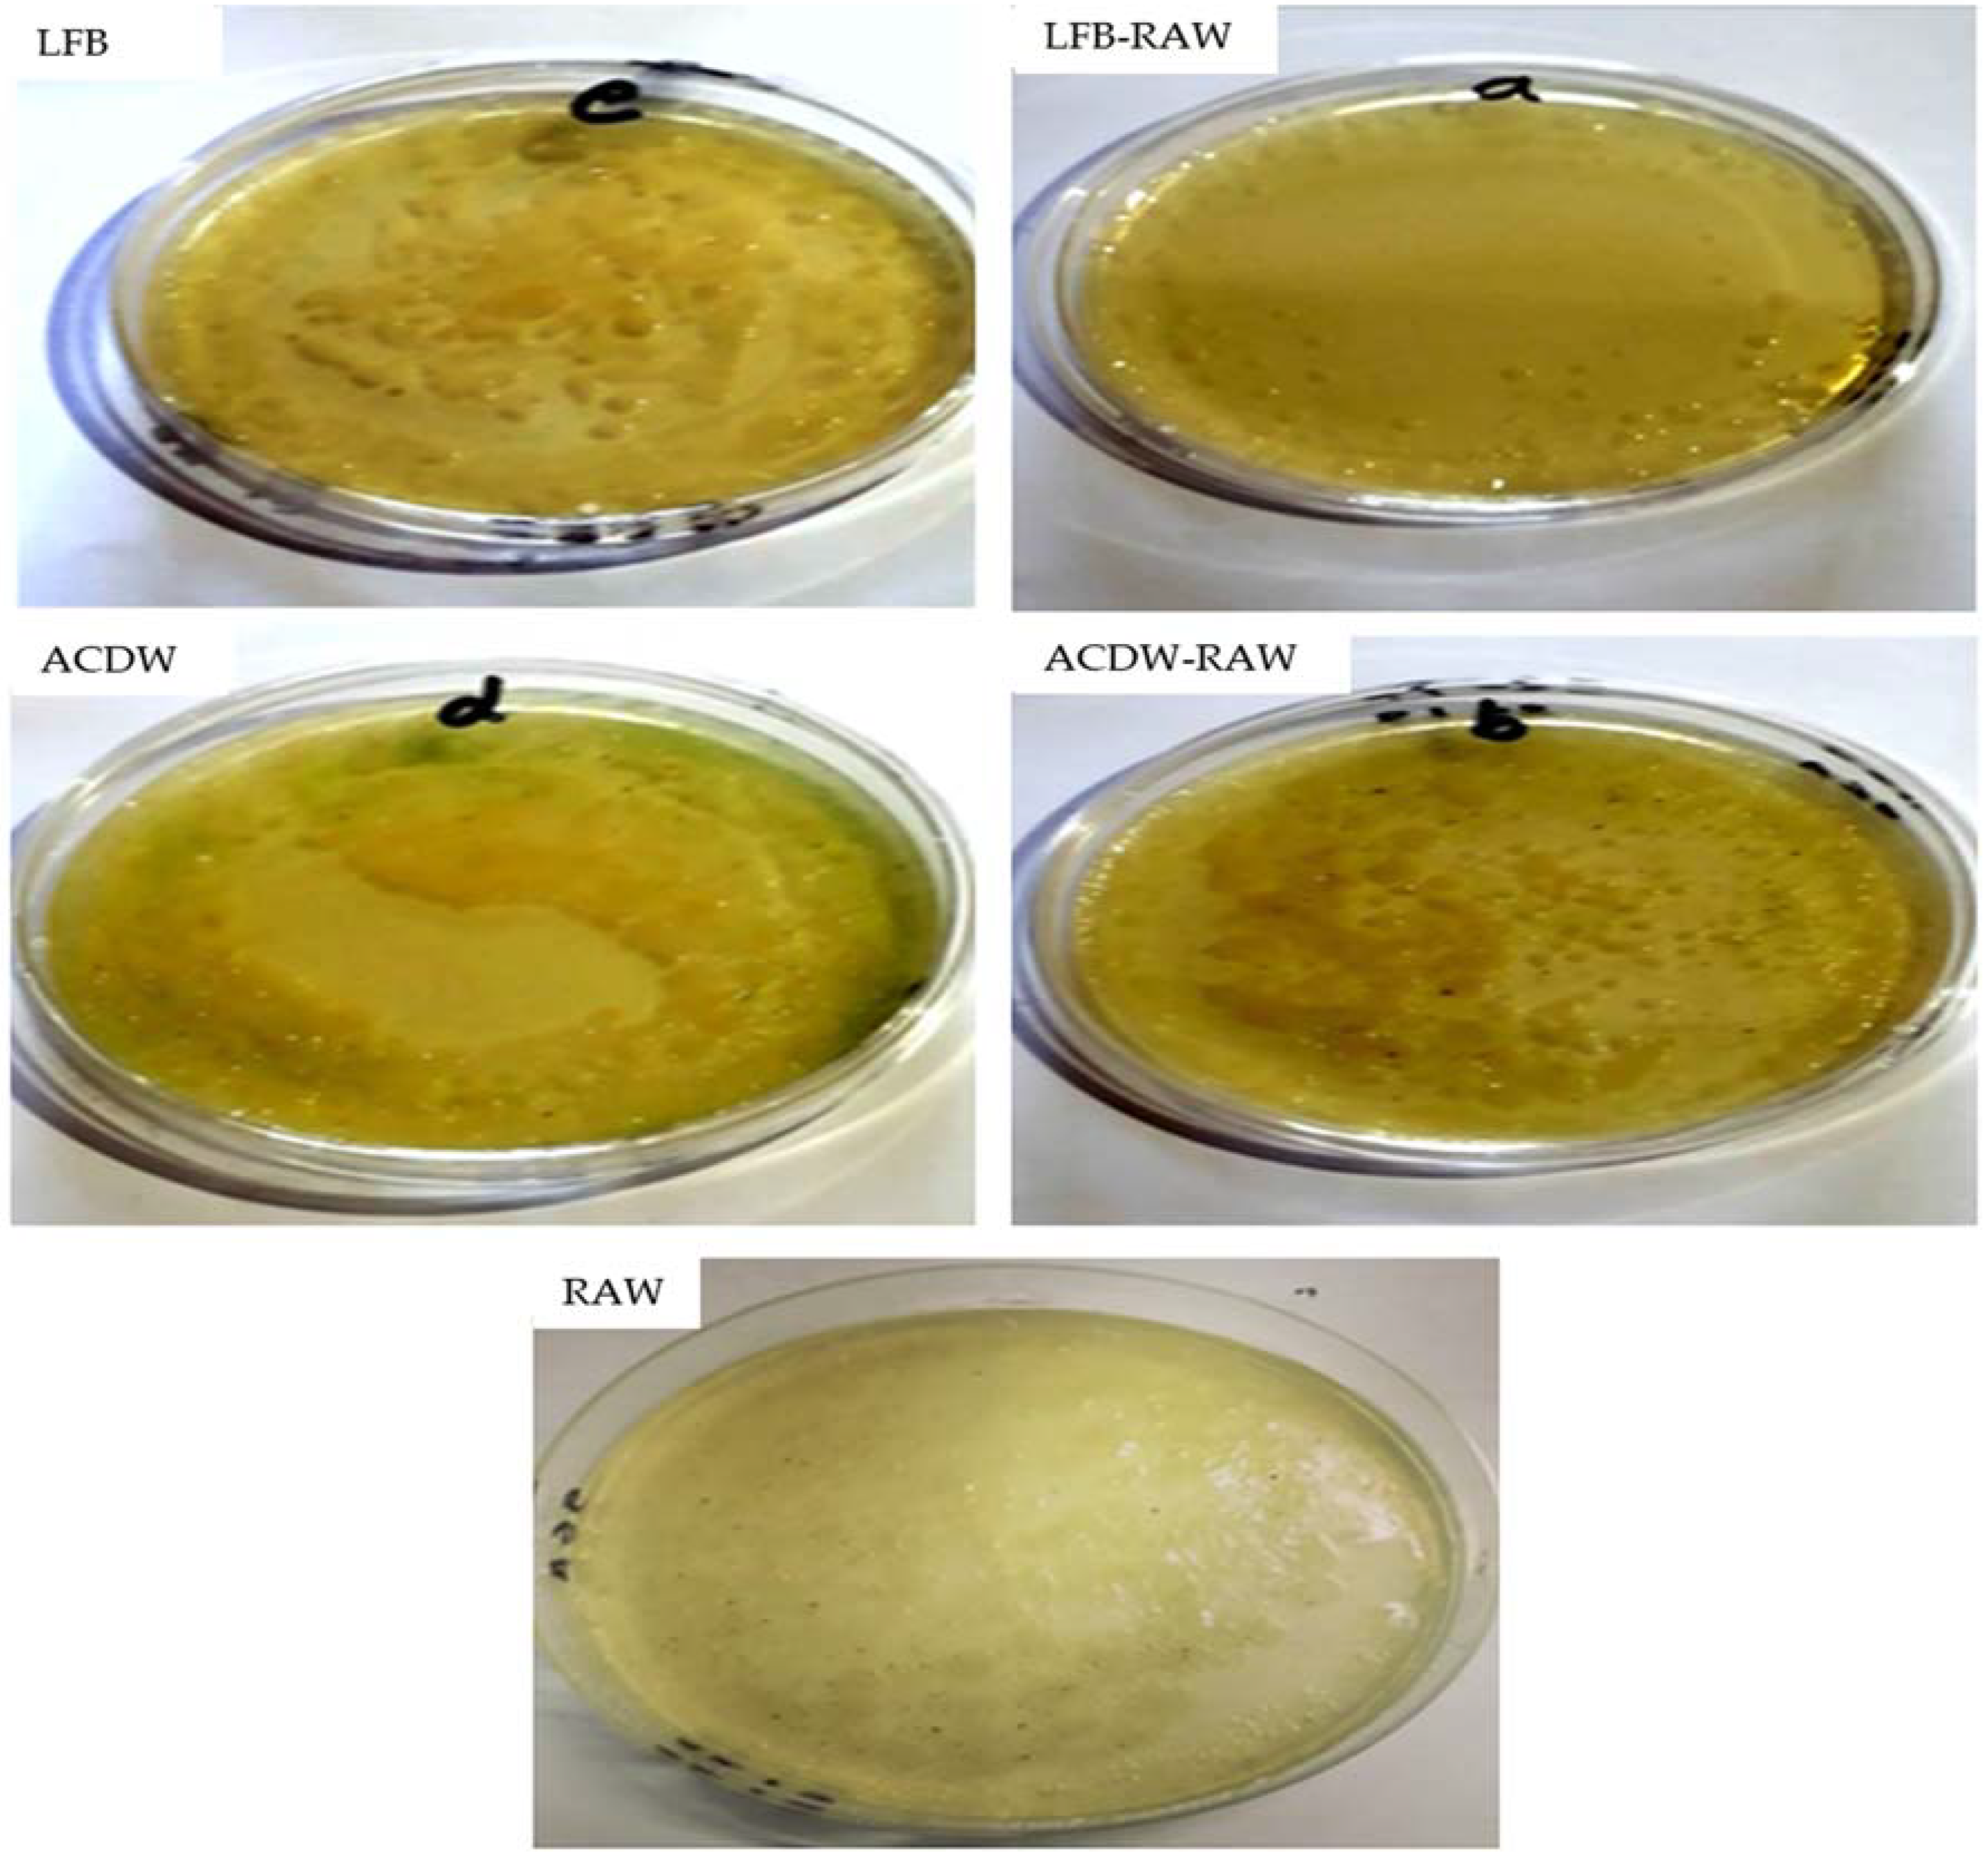

Ammonia Bioremediation from Aquaculture Wastewater Effluents Using Arthrospira platensis NIOF17/003: Impact of Biodiesel Residue and Potential of Ammonia-Loaded Biomass as Rotifer Feed
Abstract
:1. Introduction
2. Materials and Methods
2.1. Arthrospira Strain
2.2. Adsorption Experiments
2.2.1. Adsorbent Preparation
2.2.2. Isotherm Studies
2.2.3. Kinetic Study
Pseudo-First-Order Kinetic Model
Pseudo-Second-Order Kinetic Model
2.2.4. Application of Aquaculture Wastewater
2.2.5. Adsorbent Characterization
2.3. Influence of Adsorbents on the Bacterial Count
2.4. Bioassay Test
2.5. Chemicals
2.6. Statistical Analysis
3. Results and Discussion
3.1. Characterization of Adsorbents
3.1.1. FTIR Analysis
3.1.2. Raman Spectral Analysis
3.1.3. Scanning Electron Microscopy
3.2. Adsorption Studies
3.2.1. Influence of pH
3.2.2. Influence of Contact Time
3.2.3. Influence of the Adsorbent Dosage
3.2.4. Influence of Initial NH4+ Concentration
3.3. Applicability to Real Aquaculture Wastewater
3.4. Isothermal Analysis
3.5. Kinetic Analysis
3.6. Bacterial Count
3.7. Rotifer Experiment
3.8. Comparison of NH4-N Elimination by Various Species of Microalgae
4. Conclusions
Author Contributions
Funding
Institutional Review Board Statement
Informed Consent Statement
Data Availability Statement
Acknowledgments
Conflicts of Interest
References
- Mook, W.; Chakrabarti, M.; Aroua, M.K.; Khan, G.; Ali, B.; Islam, S.; Abu Hassan, M. Removal of total ammonia nitrogen (TAN), nitrate and total organic carbon (TOC) from aquaculture wastewater using electrochemical technology: A review. Desalination 2012, 285, 1–13. [Google Scholar] [CrossRef]
- Zhimiao, Z.; Xiao, Z.; Zhufang, W.; Xinshan, S.; Mengqi, C.; Mengyu, C.; Yinjiang, Z. Enhancing the pollutant removal performance and biological mechanisms by adding ferrous ions into aquaculture wastewater in constructed wetland. Bioresour. Technol. 2019, 293, 122003. [Google Scholar] [CrossRef]
- Qin, G.; Liu, C.C.; Richman, N.H.; Moncur, J.E. Aquaculture wastewater treatment and reuse by wind-driven reverse osmosis membrane technology: A pilot study on Coconut Island, Hawaii. Aquac. Eng. 2005, 32, 365–378. [Google Scholar] [CrossRef]
- Turcios, A.E.; Papenbrock, J. Sustainable Treatment of Aquaculture Effluents—What Can We Learn from the Past for the Future? Sustainability 2014, 6, 836–856. [Google Scholar] [CrossRef] [Green Version]
- Abomohra, A.E.-F.; El-Hefnawy, M.E.; Wang, Q.; Huang, J.; Li, L.; Tang, J.; Mohammed, S. Sequential bioethanol and biogas production coupled with heavy metal removal using dry seaweeds: Towards enhanced economic feasibility. J. Clean. Prod. 2021, 316, 128341. [Google Scholar] [CrossRef]
- Haider, S.; Park, S.-Y. Preparation of the electrospun chitosan nanofibers and their applications to the adsorption of Cu(II) and Pb(II) ions from an aqueous solution. J. Membr. Sci. 2009, 328, 90–96. [Google Scholar] [CrossRef]
- Seruga, P.; Krzywonos, M.; Pyżanowska, J.; Urbanowska, A.; Pawlak-Kruczek, H.; Łukasz, N. Removal of Ammonia from the Municipal Waste Treatment Effluents using Natural Minerals. Molecules 2019, 24, 3633. [Google Scholar] [CrossRef] [Green Version]
- Salbitani, G.; Carfagna, S. Ammonium Utilization in Microalgae: A Sustainable Method for Wastewater Treatment. Sustainability 2021, 13, 956. [Google Scholar] [CrossRef]
- Cheng, W.-P.; Chen, P.-H.; Yu, R.-F.; Ho, W.-N. Treating ammonium-rich wastewater with sludge from water treatment plant to produce ammonium alum. Sustain. Environ. Res. 2016, 26, 63–69. [Google Scholar] [CrossRef] [Green Version]
- Liu, Y.; Ngo, H.H.; Guo, W.; Peng, L.; Wang, D.; Ni, B. The roles of free ammonia (FA) in biological wastewater treatment processes: A review. Environ. Int. 2019, 123, 10–19. [Google Scholar] [CrossRef]
- Fito, J.; Alemu, K. Microalgae–bacteria consortium treatment technology for municipal wastewater management. Nanotechnol. Environ. Eng. 2019, 4, 4. [Google Scholar] [CrossRef]
- Curtin, K.; Fitzpatrick, B. Biological Nutrient Removal; Minnesota Pollution Control Agency: St Paul, MN, USA, 2011. [Google Scholar]
- Rezaei, H.; Rastegar, S.; Naseri, S. Application of Chitosan and Activated Carbon Nano-composite in Removal of Nitrite, Phosphate, and Ammonia from Aquaculture Wastewater. Avicenna J. Environ. Heal. Eng. 2019, 6, 106–112. [Google Scholar] [CrossRef]
- Wang, S.; Uzoejinwa, B.B.; Abomohra, A.E.-F.; Wang, Q.; He, Z.; Feng, Y.; Zhang, B.; Hui, C.-W. Characterization and pyrolysis behavior of the green microalga Micractinium conductrix grown in lab-scale tubular photobioreactor using Py-GC/MS and TGA/MS. J. Anal. Appl. Pyrolysis 2018, 135, 340–349. [Google Scholar] [CrossRef]
- Almarashi, J.Q.; El-Zohary, S.E.; Ellabban, M.; Abomohra, A.E.-F. Enhancement of lipid production and energy recovery from the green microalga Chlorella vulgaris by inoculum pretreatment with low-dose cold atmospheric pressure plasma (CAPP). Energy Convers. Manag. 2020, 204, 112314. [Google Scholar] [CrossRef]
- Lee, S.-J.; Go, S.; Jeong, G.-T.; Kim, S.-K. Oil production from five marine microalgae for the production of biodiesel. Biotechnol. Bioprocess Eng. 2011, 16, 561–566. [Google Scholar] [CrossRef]
- Hayashi, T.; Hayashi, K. Calcium spirulan, an inhibitor of enveloped virus replication, from a blue green alga Spirulina platensis. J. Nat. Prod. 1996, 59, 83–87. [Google Scholar] [CrossRef]
- Kumar, V.; Bhatnagar, A.K.; Srivastava, J.N. Antibacterial activity of crude extracts of Spirulina platensis and its structural elucidation of bioactive compound. J. Med. Plants Res. 2011, 5, 7043–7048. [Google Scholar]
- Khan, M.; Shobha, J.C.; Mohan, I.K.; Naidu, M.U.R.; Prayag, A.; Kutala, V.K. Spirulina attenuates cyclosporine-induced nephrotoxicity in rats. J. Appl. Toxicol. 2006, 26, 444–451. [Google Scholar] [CrossRef]
- Dotto, G.; Lima, E.; Pinto, L. Biosorption of food dyes onto Spirulina platensis nanoparticles: Equilibrium isotherm and thermodynamic analysis. Bioresour. Technol. 2012, 103, 123–130. [Google Scholar] [CrossRef] [Green Version]
- El Moselhy, K.M.; Azzem, M.A.; Amer, A.; Prol, A.E. Al Adsorption of Cu (II) and Cd (II) from Aqueous Solution by Using Rice Husk Adsorbent. Phys. Chem. Indian J. 2017, 12, 109. [Google Scholar]
- Farahdiba, A.U.; Budiantoro, W.; Yulianto, A. Ammonia removal from Yogyakarta Domestic Wastewater (WWTP-SEWON) by microalgae reactor with CO2 addition. IOP Conf. Ser. Earth Environ. Sci. 2019, 245, 012019. [Google Scholar] [CrossRef]
- Kim, J.; Lingaraju, B.P.; Rheaume, R.; Lee, J.-Y.; Siddiqui, K.F. Removal of ammonia from wastewater effluent by chlorella vulgaris. Tsinghua Sci. Technol. 2010, 15, 391–396. [Google Scholar] [CrossRef]
- Abbas, E.M.; Ali, F.S.; Desouky, M.G.; Ashour, M.; El-Shafei, A.; Maaty, M.M.; Sharawy, Z.Z. Novel comprehensive molecular and ecological study introducing coastal mud shrimp (Solenocera crassicornis) recorded at the Gulf of suez, Egypt. J. Mar. Sci. Eng. 2021, 9, 9. [Google Scholar] [CrossRef]
- Griffiths, E.W. DigitalCommons @ USU Removal and Utilization of Wastewater Nutrients for Algae Biomass and Biofuels. 2009. Available online: https://digitalcommons.usu.edu/etd/631/ (accessed on 10 September 2021).
- Converti, A.; Scapazzoni, S.; Lodi, A.; Carvalho, J.C.M. Ammonium and urea removal by Spirulina platensis. J. Ind. Microbiol. Biotechnol. 2006, 33, 8–16. [Google Scholar] [CrossRef]
- Voltolina, D. Nitrogen removal and recycling by Scenedesmus obliquus in semicontinuous cultures using artificial wastewater and a simulated light and temperature cycle. Bioresour. Technol. 2005, 96, 359–362. [Google Scholar] [CrossRef]
- Lu, Q.; Zhou, W.; Min, M.; Ma, X.; Ma, Y.; Chen, P.; Zheng, H.; Doan, Y.; Liu, H.; Chen, C.; et al. Mitigating ammonia nitrogen deficiency in dairy wastewaters for algae cultivation. Bioresour. Technol. 2016, 201, 33–40. [Google Scholar] [CrossRef]
- Kang, J. Mitigation of ammonia gas from animal house using microalgae. In Mitigation of Ammonia Gas From Animal House Using Microalgae; 2018; Available online: https://lib.dr.iastate.edu/etd/12782/ (accessed on 10 September 2021).
- Zaki, M.; Ashour, M.; Heneash, A.; Mabrouk, M.; Alprol, A.; Khairy, H.; Nour, A.; Mansour, A.; Hassanien, H.; Gaber, A.; et al. Potential Applications of Native Cyanobacterium Isolate (Arthrospira platensis NIOF17/003) for Biodiesel Production and Utilization of Its Byproduct in Marine Rotifer (Brachionus plicatilis) Production. Sustainability 2021, 13, 1769. [Google Scholar] [CrossRef]
- Alprol, A.; Heneash, A.; Ashour, M.; Abualnaja, K.; Alhashmialameer, D.; Mansour, A.; Sharawy, Z.; Abu-Saied, M.; Abomohra, A. Potential Applications of Arthrospira platensis Lipid-Free Biomass in Bioremediation of Organic Dye from Industrial Textile Effluents and Its Influence on Marine Rotifer (Brachionus plicatilis). Materials 2021, 14, 4446. [Google Scholar] [CrossRef] [PubMed]
- Zarrouk, C. Contribution a l’etude d’une Cyanophycee. Influence de Divers Facteurs Physiques et Chimiques sur la Croissance et la Photosynthese de Spirulina Mixima. Master’s Thesis, University of Paris, Paris, France, 1966. [Google Scholar]
- Federation, A.; Association, A. Standard Methods for the Examination of Water and Wastewater; American Public Health Association (APHA): Washington, DC, USA, 2005. [Google Scholar]
- Grasshoff, K.; Kremling, K.; Ehrhardt, M. Methods of Sea Water Analysis, 3rd ed.; Weinheim, Ed.; Wiley-VCH: New York, NY, USA, 1999. [Google Scholar]
- Ghoneim, M.M.; El-Desoky, H.S.; El-Moselhy, K.M.; Amer, A.; El-Naga, E.H.A.; Mohamedein, L.; Al-Prol, A.E. Removal of cadmium from aqueous solution using marine green algae, Ulva lactuca. Egypt. J. Aquat. Res. 2014, 40, 235–242. [Google Scholar] [CrossRef] [Green Version]
- Freundlich, H.M.F. Over the adsorption in solution. J. Phys. Chem. 1906, 57, 1100–1107. [Google Scholar]
- Langmuir, I. The constitution and fundamental properties of solids and liquids. Part II.—Liquids. J. Frankl. Inst. 1917, 184, 721. [Google Scholar] [CrossRef]
- Halsey, G. Physical Adsorption on Non-Uniform Surfaces. J. Chem. Phys. 1948, 16, 931–937. [Google Scholar] [CrossRef]
- Kumar, Y.P.; King, P.; Prasad, V. Removal of copper from aqueous solution using Ulva fasciata sp.—A marine green algae. J. Hazard. Mater. 2006, 137, 367–373. [Google Scholar] [CrossRef] [PubMed]
- Al-Aoh, H.A.; Yahya, R.; Maah, M.J.; Bin Abas, M.R. Adsorption of methylene blue on activated carbon fiber prepared from coconut husk: Isotherm, kinetics and thermodynamics studies. Desalination Water Treat. 2013, 52, 6720–6732. [Google Scholar] [CrossRef]
- Ho, Y.; McKay, G. Pseudo-second order model for sorption processes. Process. Biochem. 1999, 34, 451–465. [Google Scholar] [CrossRef]
- Yahaya, T.; Doherty, V.; Akinola, O.; Shamsudeen, A. Heavy metal profiles and microbial counts of selected sachet water brands in Birnin Kebbi Metropolis, Nigeria. Ife J. Sci. 2019, 21, 229. [Google Scholar] [CrossRef]
- Ashour, M.; Elshobary, M.E.; El-Shenody, R.; Kamil, A.; El-Fatah, A. Evaluation of a native oleaginous marine microalga Nannochloropsis oceanica for dual use in biodiesel production and aquaculture feed. Biomass Bioenergy 2019, 120, 439–447. [Google Scholar] [CrossRef]
- Inyinbor, A.; Adekola, F.; Olatunji, G. Kinetics, isotherms and thermodynamic modeling of liquid phase adsorption of Rhodamine B dye onto Raphia hookerie fruit epicarp. Water Resour. Ind. 2016, 15, 14–27. [Google Scholar] [CrossRef] [Green Version]
- Gong, R.; Ding, Y.; Liu, H.; Chen, Q.; Liu, Z. Lead biosorption and desorption by intact and pretreated spirulina maxima biomass. Chemosphere 2005, 58, 125–130. [Google Scholar] [CrossRef]
- Cardoso, N.F.; Pinto, R.B.; Lima, E.C.; Calvete, T.; Amavisca, C.V.; Royer, B.; Cunha, M.L.; Fernandes, T.H.; Pinto, I.S. Removal of remazol black B textile dye from aqueous solution by adsorption. Desalination 2011, 269, 92–103. [Google Scholar] [CrossRef]
- Calvete, T.; Lima, E.C.; Cardoso, N.F.; Dias, S.L.; Pavan, F.A. Application of carbon adsorbents prepared from the Brazilian pine-fruit-shell for the removal of Procion Red MX 3B from aqueous solution—Kinetic, equilibrium, and thermodynamic studies. Chem. Eng. J. 2009, 155, 627–636. [Google Scholar] [CrossRef]
- Abualnaja, K.; Alprol, A.; Abu-Saied, M.; Mansour, A.; Ashour, M. Studying the Adsorptive Behavior of Poly(Acrylonitrile-co-Styrene) and Carbon Nanotubes (Nanocomposites) Impregnated with Adsorbent Materials towards Methyl Orange Dye. Nanomaterials 2021, 11, 1144. [Google Scholar] [CrossRef] [PubMed]
- Abualnaja, K.; Alprol, A.; Abu-Saied, M.; Ashour, M.; Mansour, A. Removing of Anionic Dye from Aqueous Solutions by Adsorption Using of Multiwalled Carbon Nanotubes and Poly (Acrylonitrile-styrene) Impregnated with Activated Carbon. Sustainability 2021, 13, 7077. [Google Scholar] [CrossRef]
- Peterson, H.C.; Healey, F.P.; Wagernann, R. Metal toxicity to algae: A highly pH dependent phenomenon. Can. J. Fish Aquat. Sci. 1984, 41, 974–979. [Google Scholar] [CrossRef]
- Abualnaja, K.; Alprol, A.; Ashour, M.; Mansour, A. Influencing Multi-Walled Carbon Nanotubes for the Removal of Ismate Violet 2R Dye from Wastewater: Isotherm, Kinetics, and Thermodynamic Studies. Appl. Sci. 2021, 11, 4786. [Google Scholar] [CrossRef]
- Montalvo, S.; Huiliñir, C.; Borja, R.; Sánchez, E.; Herrmann, C. Application of zeolites for biological treatment processes of solid wastes and wastewaters—A review. Bioresour. Technol. 2020, 301, 122808. [Google Scholar] [CrossRef]
- Putra, W.P.; Kamari, A.; Najiah, S.; Yusoff, M.; Ishak, C.F. Biosorption of Cu (II), Pb (II) and Zn (II) Ions from Aqueous Solutions Using Selected Waste Materials: Adsorption and Characterisation Studies. J. Encapsulation Adsorpt. Sci. 2014, 2014, 25–35. [Google Scholar] [CrossRef] [Green Version]
- Nogueira, S.M.S.; Junior, J.S.; Maia, H.D.; Saboya, J.P.S.; Farias, W.R.L. Use of Spirulina platensis in treatment of fish farming wastewater. Rev. Ciência Agronômica 2018, 49, 599–606. [Google Scholar] [CrossRef]
- Liu, Y.; Lv, J.; Feng, J.; Liu, Q.; Nan, F.; Xie, S. Treatment of real aquaculture wastewater from a fishery utilizing phytoremediation with microalgae. J. Chem. Technol. Biotechnol. 2019, 94, 900–910. [Google Scholar] [CrossRef]
- Wuang, S.C.; Khin, M.C.; Chua, P.Q.D.; Luo, Y.D. Use of Spirulina biomass produced from treatment of aquaculture wastewater as agricultural fertilizers. Algal Res. 2016, 15, 59–64. [Google Scholar] [CrossRef]
- Shen, Y.; Gao, J.; Li, L. Municipal wastewater treatment via co-immobilized microalgal-bacterial symbiosis: Microorganism growth and nutrients removal. Bioresour. Technol. 2017, 243, 905–913. [Google Scholar] [CrossRef] [PubMed]
- Delgadillo-Mirquez, L.; Lopes, F.; Taidi, B.; Pareau, D. Nitrogen and phosphate removal from wastewater with a mixed microalgae and bacteria culture. Biotechnol. Rep. 2016, 11, 18–26. [Google Scholar] [CrossRef]
- Blaby-Haas, C.E.; Merchant, S.S. The ins and outs of algal metal transport. Biochim. Biophys. Acta BBA-Bioenerg. 2012, 1823, 1531–1552. [Google Scholar] [CrossRef] [Green Version]
- Gaignard, C.; Laroche, C.; Pierre, G.; Dubessay, P.; Delattre, C.; Gardarin, C.; Gourvil, P.; Probert, I.; Dubuffet, A.; Michaud, P. Screening of marine microalgae: Investigation of new exopolysaccharide producers. Algal Res. 2019, 44, 101711. [Google Scholar] [CrossRef]
- Lau, P.S.; Lee, H.Y.; Tsang, C.K.; Tam, N.Y.; Wong, Y.S. Effect of Metal Interference, pH and Temperature on Cu and Ni Biosorption by Chlorella Vulgaris and Chlorella Miniata. Environ. Technol. 1999, 20, 953–961. [Google Scholar] [CrossRef]
- Wang, L.; Xiao, H.; He, N.; Sun, D.; Duan, S. Biosorption and Biodegradation of the Environmental Hormone Nonylphenol by Four Marine Microalgae. Sci. Rep. 2019, 9, 5277. [Google Scholar] [CrossRef]
- Elshobary, M.E.; El-Shenody, R.A.; Ashour, M.; Zabed, H.M.; Qi, X. Antimicrobial and antioxidant characterization of bioactive components from Chlorococcum minutum. Food Biosci. 2020, 35, 100567. [Google Scholar] [CrossRef]
- Ashour, M.; El-Shafei, A.A.; Khairy, H.M.; Abd-Elkader, D.Y.; Mattar, M.A.; Alataway, A.; Hassan, S.M. Effect of Pterocladia capillacea Seaweed Extracts on Growth Parameters and Biochemical Constituents of Jew’s Mallow. Agronomy 2020, 10, 420. [Google Scholar] [CrossRef] [Green Version]
- Ashour, M.; Hassan, S.; Elshobary, M.; Ammar, G.; Gaber, A.; Alsanie, W.; Mansour, A.; El-Shenody, R. Impact of Commercial Seaweed Liquid Extract (TAM®) Biostimulant and Its Bioactive Molecules on Growth and Antioxidant Activities of Hot Pepper (Capsicum annuum). Plants 2021, 10, 1045. [Google Scholar] [CrossRef]
- Hassan, S.; Ashour, M.; Soliman, A.; Hassanien, H.; Alsanie, W.; Gaber, A.; Elshobary, M. The Potential of a New Commercial Seaweed Extract in Stimulating Morpho-Agronomic and Bioactive Properties of Eruca vesicaria (L.) Cav. Sustainability 2021, 13, 4485. [Google Scholar] [CrossRef]
- Hassan, S.; Ashour, M.; Sakai, N.; Zhang, L.; Hassanien, H.; Gaber, A.; Ammar, G. Impact of Seaweed Liquid Extract Biostimulant on Growth, Yield, and Chemical Composition of Cucumber (Cucumis sativus). Agriculture 2021, 11, 320. [Google Scholar] [CrossRef]
- Ashour, M.; Mabrouk, M.M.; Abo-Taleb, H.A.; Sharawy, Z.; Ayoub, H.F.; Van Doan, H.; Davies, S.J.; El-Haroun, E.; Goda, A.M.-A. A liquid seaweed extract (TAM®) improves aqueous rearing environment, diversity of zooplankton community, whilst enhancing growth and immune response of Nile tilapia, Oreochromis niloticus, challenged by Aeromonas hydrophila. Aquaculture 2021, 543, 736915. [Google Scholar] [CrossRef]
- Ashour, M.; Mabrouk, M.M.; Ayoub, H.F.; El-Feky, M.M.; Zaki, S.Z.; Hoseinifar, S.H.; Rossi, W.; Van Doan, H.; El-Haroun, E.; Goda, A.M.-S. Effect of dietary seaweed extract supplementation on growth, feed utilization, hematological indices, and non-specific immunity of Nile Tilapia, Oreochromis niloticus challenged with Aeromonas hydrophila. Environ. Boil. Fishes 2020, 32, 3467–3479. [Google Scholar] [CrossRef]
- Sharawy, Z.Z.; Ashour, M.; Abbas, E.; Ashry, O.; Helal, M.; Nazmi, H.; Kelany, M.; Kamel, A.; Hassaan, M.; Rossi, W., Jr.; et al. Effects of dietary marine microalgae, Tetraselmis suecica, on production, gene expression, protein markers and bacterial count of Pacific white shrimp Litopenaeus vannamei. Aquac. Res. 2020, 51, 2216–2228. [Google Scholar] [CrossRef]
- El-Shenody, R.A.; Ashour, M.; Ghobara, M.M.E. Evaluating the chemical composition and antioxidant activity of three Egyptian seaweeds: Dictyota dichotoma, Turbinaria decurrens, and Laurencia obtusa. Braz. J. Food Technol. 2019, 22, 22. [Google Scholar] [CrossRef] [Green Version]
- Shao, W.; Ebaid, R.; El-Sheekh, M.; Abomohra, A.; Eladel, H. Pharmaceutical applications and consequent environmental impacts of Spirulina (Arthrospira): An overview. Grasas Aceites 2019, 70, 292. [Google Scholar] [CrossRef] [Green Version]
- Han, S.; Jin, W.; Chen, Y.; Tu, R.; Abomohra, A.E.-F. Enhancement of Lipid Production of Chlorella Pyrenoidosa Cultivated in Municipal Wastewater by Magnetic Treatment. Appl. Biochem. Biotechnol. 2016, 180, 1043–1055. [Google Scholar] [CrossRef]
- Noaman, N.H.; Fattah, A.; Khaleafa, M.; Zaky, S.H. Factors affecting antimicrobial activity of Synechococcus leopoliensis. Microbiol. Res. 2004, 159, 395–402. [Google Scholar] [CrossRef] [PubMed]
- Abomohra, A.E.-F.; Zheng, X.; Wang, Q.; Huang, J.; Ebaid, R. Enhancement of biodiesel yield and characteristics through in-situ solvo-thermal co-transesterification of wet microalgae with spent coffee grounds. Bioresour. Technol. 2021, 323, 124640. [Google Scholar] [CrossRef]
- Abomohra, A.E.-F.; El-Sheekh, M.; Hanelt, D. Pilot cultivation of the chlorophyte microalga Scenedesmus obliquus as a promising feedstock for biofuel. Biomass- Bioenergy 2014, 64, 237–244. [Google Scholar] [CrossRef]
- Rechter, S.; König, T.; Auerochs, S.; Thulke, S.; Walter, H.; Dörnenburg, H.; Walter, C.; Marschall, M. Antiviral activity of Arthrospira-derived spirulan-like substances. Antivir. Res. 2006, 72, 197–206. [Google Scholar] [CrossRef]
- Kokou, F.; Makridis, P.; Kentouri, M.; Divanach, P.; Makridis, P. Antibacterial activity in microalgae cultures. Aquac. Res. 2011, 43, 1520–1527. [Google Scholar] [CrossRef]
- Moraes de Souza, M.; Prietto, L.; Ribeiro, A.C.D.; de Souza, T.B.-F.E. Assessment of the antifungal activity of Spirulina platensis phenolic extract against Aspergillus flavus. Cienc. Agrotecnologia 2011, 35, 1050–1058. [Google Scholar] [CrossRef] [Green Version]
- Ashour, M.; Abo-Taleb, H.; Abou-Mahmoud, M.; El-Feky, M.M.M. Effect of the integration between plankton natural productivity and environmental assessment of irrigation water, El-Mahmoudia Canal, on aquaculture potential of Oreochromis niloticus. Turk. J. Fish. Aquat. Sci. 2018, 18, 1163–1175. [Google Scholar] [CrossRef]
- Alprol, A.; Heneash, A.; Soliman, A.; Ashour, M.; Alsanie, W.; Gaber, A.; Mansour, A. Assessment of Water Quality, Eutrophication, and Zooplankton Community in Lake Burullus, Egypt. Diversity 2021, 13, 268. [Google Scholar] [CrossRef]
- Heneash, A.M.; Alprol, A.E.; El-Hamid, H.T.A.; Khater, M.; El Damhogy, K.A. Assessment of water pollution induced by anthropogenic activities on zooplankton community in Mariout Lake using statistical simulation. Arab. J. Geosci. 2021, 14, 641. [Google Scholar] [CrossRef]
- Abo-Taleb, H.; Ashour, M.; El-Shafei, A.; Alataway, A.; Maaty, M.M.; Abo-Taleb, H. Biodiversity of Calanoida Copepoda in Different Habitats of the North-Western Red Sea (Hurghada Shelf). Water 2020, 12, 656. [Google Scholar] [CrossRef] [Green Version]
- Doson, S. Predicting crustacean zooplankton species richness. Limnol. Oceanog. 1992, 37, 848–856. [Google Scholar] [CrossRef]
- Olguín, E.J.; Galicia, S.; Mercado, G.; Pérez, T. Annual productivity of Spirulina (Arthrospira) and nutrient removal in a pig wastewater recycling process under tropical conditions. Environ. Boil. Fishes 2003, 15, 249–257. [Google Scholar] [CrossRef]
- Zhou, W.; Li, Y.; Gao, Y.; Zhao, H. Nutrients removal and recovery from saline wastewater by Spirulina platensis. Bioresour. Technol. 2017, 245, 10–17. [Google Scholar] [CrossRef]
- Boussiba, S. Ammonia Uptake in the Alkalophilic Cyanobacterium Spirulina platensis1. Plant. Cell Physiol. 1989, 30, 303–308. [Google Scholar] [CrossRef]
- Pham, T.-L.; Bui, M.H. Removal of Nutrients from Fertilizer Plant Wastewater Using Scenedesmus sp.: Formation of Bioflocculation and Enhancement of Removal Efficiency. J. Chem. 2020, 2020, 8094272. [Google Scholar] [CrossRef] [Green Version]
- Kobayashi, N.; Noel, E.A.; Barnes, A.; Watson, A.; Rosenberg, J.N.; Erickson, G.; Oyler, G.A. Characterization of three Chlorella sorokiniana strains in anaerobic digested effluent from cattle manure. Bioresour. Technol. 2013, 150, 377–386. [Google Scholar] [CrossRef] [PubMed] [Green Version]

| Types of Water | Ammonium Ions Removal (%) | |
|---|---|---|
| ACDW | LFB | |
| Synthetic aqueous solution | 64.24 | 89.68 |
| Real aquaculture effluent | 25.70 | 37.80 |
| Isotherm Models | Parameters | ACDW | LFB |
|---|---|---|---|
| Freundlich Model | R2 | 0.914 | 0.987 |
| 1/n | 1.463 | 1.279 | |
| Kf | 10.73 | 3.16 | |
| Langmuir Model | R2 | 0.937 | 0.985 |
| qmax (mg·g−1) | 0.379 | 0.745 | |
| Halsey Model | R2 | 0.884 | 0.213 |
| 1/nH | 2.797 | 0.390 | |
| KH | 2.884 | 1.64 |
| First-Order Kinetic | Second-Order Kinetic | ||||
|---|---|---|---|---|---|
| Adsorbent | K1 (1 min) | R2 | qe Calc. (mg·g−1) | K2 (g·mg−1·min−1) | R2 |
| ACWD | 122.24 | 0.337 | 1.65 | 0.604 | 0.999 |
| LFB | 0.0034 | 0.239 | 3.379 | 0.295 | 0.996 |
| Bacterial Count | Groups |
|---|---|
| Higher than 300 CFU | LFB |
| Less than 100 CFU | LFB-RAW |
| Higher than 300 CFU | ACDW |
| Higher than 300 CFU | ACDW-RAW |
| Higher than 300 CFU | RAW |
| Species (Microalgae) | NH4-N Removal | Reference |
|---|---|---|
| Spirulina (Arthrospira) | 84–96% | [85] |
| Spirulina sp. | 79% | [86] |
| Spirulina platensis | 80% | [87] |
| Chlorella sp. | 18% | [11] |
| Scenedesmus sp. | 71–92.8% | [88] |
| Scenedesmus obliquus | 66–73% | [27] |
| Chlorella sorokiniana | 75% | [89] |
| Arthrospira platensis (ACDW) | 64% | This study |
| Arthrospira platensis (LFB) | 89% | This study |
Publisher’s Note: MDPI stays neutral with regard to jurisdictional claims in published maps and institutional affiliations. |
© 2021 by the authors. Licensee MDPI, Basel, Switzerland. This article is an open access article distributed under the terms and conditions of the Creative Commons Attribution (CC BY) license (https://creativecommons.org/licenses/by/4.0/).
Share and Cite
Ashour, M.; Alprol, A.E.; Heneash, A.M.M.; Saleh, H.; Abualnaja, K.M.; Alhashmialameer, D.; Mansour, A.T. Ammonia Bioremediation from Aquaculture Wastewater Effluents Using Arthrospira platensis NIOF17/003: Impact of Biodiesel Residue and Potential of Ammonia-Loaded Biomass as Rotifer Feed. Materials 2021, 14, 5460. https://doi.org/10.3390/ma14185460
Ashour M, Alprol AE, Heneash AMM, Saleh H, Abualnaja KM, Alhashmialameer D, Mansour AT. Ammonia Bioremediation from Aquaculture Wastewater Effluents Using Arthrospira platensis NIOF17/003: Impact of Biodiesel Residue and Potential of Ammonia-Loaded Biomass as Rotifer Feed. Materials. 2021; 14(18):5460. https://doi.org/10.3390/ma14185460
Chicago/Turabian StyleAshour, Mohamed, Ahmed E. Alprol, Ahmed M. M. Heneash, Hosam Saleh, Khamael M. Abualnaja, Dalal Alhashmialameer, and Abdallah Tageldein Mansour. 2021. "Ammonia Bioremediation from Aquaculture Wastewater Effluents Using Arthrospira platensis NIOF17/003: Impact of Biodiesel Residue and Potential of Ammonia-Loaded Biomass as Rotifer Feed" Materials 14, no. 18: 5460. https://doi.org/10.3390/ma14185460
APA StyleAshour, M., Alprol, A. E., Heneash, A. M. M., Saleh, H., Abualnaja, K. M., Alhashmialameer, D., & Mansour, A. T. (2021). Ammonia Bioremediation from Aquaculture Wastewater Effluents Using Arthrospira platensis NIOF17/003: Impact of Biodiesel Residue and Potential of Ammonia-Loaded Biomass as Rotifer Feed. Materials, 14(18), 5460. https://doi.org/10.3390/ma14185460








